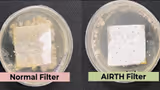
Recommended image2

A team of researchers at the Department of Inorganic and Physical Chemistry (IPC), IISc, have designed a new chiral aminoborane molecule that exhibits persistent room-temperature phosphorescence and circularly polarised luminescence (CPL).
From invisible inks to futuristic display systems, materials that emit light long after the lights go out have become essential for high-security applications and cutting-edge sensors. Yet, most of these glow-in-the-dark materials rely on inorganic phosphors or heavy metal complexes—solutions that are costly, biologically unsuitable, and environmentally harsh.

Enter the next generation of glow: A revolutionary organic molecule designed by researchers at the Department of Inorganic and Physical Chemistry (IPC), Indian Institute of Science (IISc), which not only glows persistently at room temperature but also emits circularly polarised light—a feature long sought-after for encrypted displays and advanced optical systems.
In their study published in Communications Chemistry, the IISc team introduced a novel chiral aminoborane compound that marks a significant leap in the world of organic photonics. With a structure that is both metal-free and structurally rigid, this molecule offers long-lived phosphorescence and rare circularly polarised luminescence (CPL)—without the need for extreme cooling or complex metal scaffolds.
Demonstrating real-world potential, the team transformed these molecules into anti-counterfeiting inks. One example: Under UV light, the ink displays the number ‘1180’—but once the light is turned off, the hidden text ‘IISc’ glows into view. This time-gated visibility, where different images appear in light and dark, could redefine secure labelling, tamper-proof tagging, and covert information storage.
But what enables such magic?
“When we shine light on a molecule in the stable ‘ground’ state, it gains energy and becomes excited. It can lose this energy by moving or hitting other molecules, without emitting light. Alternatively, it can return to the ground state quickly by giving off light in a process called fluorescence. Sometimes, through a rare phenomenon called ‘intersystem crossing,’ the molecule shifts from a singlet state, in which its electron spins are paired, to a triplet state, in which electron spins are unpaired and at a higher energy, before emitting light and returning to the ground state. Since this shift involves a change in spin, it is slower, and the light emitted lasts longer. This type of emission is called phosphorescence.”
Phosphorescence typically requires cryogenic conditions, as molecular motion at room temperature disrupts the long-lived glow. But the IISc team cracked this puzzle by crafting a molecule that is both rigid and delicately engineered.
The secret lies in locking two naphthalene-based chromophores around a boron-nitrogen (B–N) axis, curbing molecular jostling and preventing premature energy loss.
“The B–N bond has the same structural properties as a C–C bond, but it blesses the molecule with excited states having different symmetries,” explains P Thilagar, Professor at IPC and corresponding author. “This enhances spin flipping and promotes intersystem crossing, enabling efficient phosphorescence at room temperature.”
The molecule’s rigid chiral design allowed it to emit circularly polarised light—an exceedingly rare phenomenon in purely organic materials.
“CPL is one of the most intriguing aspects of this molecule,” adds Jusaina Eyyathiyil, PhD student at IPC and first author of the study. “It’s a difficult phenomenon to observe in organic systems due to their typically low emission efficiency. However, with support from our collaborators, we were able to achieve it.”
Synthesising the molecule, however, was a formidable task. “The formation of the B–N bond is highly sensitive to moisture and oxygen, and required strictly controlled conditions,” says Eyyathiyil. The team had to perform the reaction with flammable n-butyllithium under an inert atmosphere chilled to -78°C. For structural analysis, they partnered with researchers at the University of Trieste, Italy, using synchrotron radiation to confirm the crystal structure.
Looking forward, the team aims to boost emission efficiency and adapt the molecule for bioimaging and other photonic technologies.
“With precise molecular design, we’re beginning to bridge the gap between structural rigidity and multi-functional emission,” says Thilagar. “This work adds a new chapter to the ongoing story of small organic phosphors.”
(Inputs from IISc press release)